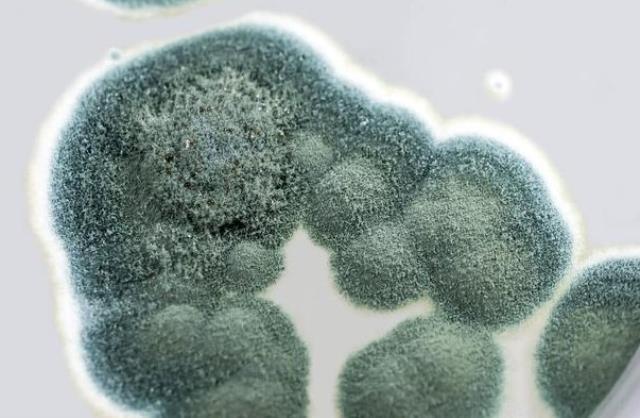
Bir kadının manavdan aldığı küflenmiş kavun, kanlı savaşın seyrini değiştirdi
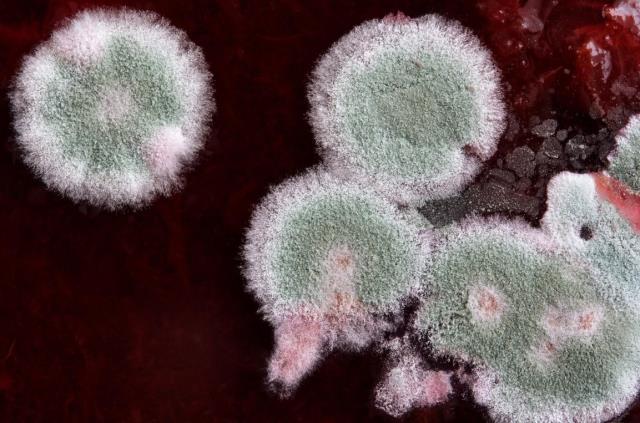
Bir kadının manavdan aldığı küflenmiş kavun, kanlı savaşın seyrini değiştirdi

Bir kadının manavdan aldığı küflenmiş kavun, kanlı savaşın seyrini değiştirdi
Haber Videosunu İzle 
Tıp dünyasının en eski antibiyotiklerinden olan ve milyonlarca insanın hayatını kurtaran penisilinin bir tesadüf üzerine bulunduğunu biliyor muydunuz? 1925'te İskoç bilim insanı Alexander Fleming'in labaratuarını düzenlerken geçmiş çalışmasının üzerinde küfte keşfettiği daha sonra, Mary Hunt adlı bilim insanı manavdan küflenmiş bir kavun üzerinde binlercesini bulduğu penisilin 1944'teki savaşın seyrini dahi değiştirmişti.
Dünyanın en eski antibiyotiklerden olan penisilin bakteriyel enfeksiyonlara karşı kullanılmış olan ilk ilaç. Bulunuşu bir hayli ilginç olan bu öenmli antibiyotik, enfeksiyonlara karşı güçlü etkilerinin ve toksik etkilerinin az olması nedeniyle çok kullanılır. Peki penisilin nasıl bulundu ve milyonların hayatını nasıl kurtardı.
YARALANIP ÖLEN ASKERLER İÇİN ÇÖZÜM ARAYIŞI BAŞLADI
1944'te gerçekleşen savaşa 30'dan fazla ülkeden gelen 100 milyondan fazla personel doğrudan katıldı. Kıran kırana geçen savaşta çoğu asker yaralanıp enfeksiyondan dolayı hayatını kaybediyordu. Bilim insanları ise askerlerin hayatını kurtarmak için canla başla çalışıyordu.

SAVAŞIN SEYRİNİ DEĞİŞTİRDİ
Yaralanan, enfeksiyon kapan, hastalanan askerlere anında çözüm bulmak çok zordu. Tam o yıllarda dünyada gerçekleşen bir ilkle milyonlarca insanın hayatı kurtuldu. Manavdan alınan küflenmiş bir kavun 1944 yılında bitmesine aylar kala II. Dünya Savaşı'nın seyrini değiştirdi.

LABARATUARINI DÜZENLERKEN FARK ETTİ
Penisilin, 1928 yılında Londra'da Alexander Fleming tarafından "Penicillium notatum" türü küfte keşfedilen antibiyotik. Penisilini bulan İskoç bakteriyolog Alexander Fleming, Londra'daki Aziz Mary's Hastanesi'nde 1914-1948 yılları arasında bilim çalışmalarında bulundu. Laboratuarının dağınıklığını düzenlerken geçmiş deneyinin değişimini fark ederek penisilini keşfetti. Ancak penisilini geliştirip insanların hizmetine sunmaya imkanları yetmedi.

TEDAVİSİ KANITLANDI
Penisilinin uygulanabilir ve seri üretilen bir ilaca dönüşmesine Howard Florey, Ernst Chain ve Norman Heatley öncülük etti. Oxford Üniversitesi'nden Howard Florey ve Ernst Chain yönetimindeki patoloji grubu, Fleming'in penisilinle ilgili çalışmalarını inceleyerek yeniden araştırmaya girişti. Grup yaptığı çeşitli deneyler sonucunda, penisilin adı verilen etkin maddeyi 1939 yılında saflaştırmayı başardı. Howard Florey ile Ernst Chain küf mantarlarını kullanarak düşük miktarda saf bir penisilin elde etmenin yolunu bulmuşlardı. Keşiflerinin ardından bir yıl geçti ve geçen süre boyunca çalışmalar daha güvenilir hale geldi.

1940 yılında bilim insanları fareler üzerinde test yapmaya karar verdi. 8 farenin hepsine ölümcül enfeksiyon enjekte eden bilim insanları, 4 fareye geliştirdikleri penisilini enjekte etti. Yapılan çalışma sonucundan penisilin almayan farelerin hepsi öldü diğerleri hayatta kaldı. Böylelikle penisilinin tedavisi kanıtlandı.

KÜFLENMİŞ KAVUNDAN GELEN MUCİZE
Penisilinin bululuyla birlikte o yıllarda salgın hastalıklar da yayılmaya başladı. ABD, askerleri için bu ilacın ihtiyaç olduğunu düşünse de ilaç seri üretilemiyordu. Howard Florey ve Ernst Chain gibi bilim insanlarının olduğu bir ekip ABD'ye gitti ve penisilini hızlıca üretmenin yolunu aradılar. Tam o sırada ABD'deki bir laboratuvarda çalışan Mary Hunt adlı bilim insanı manavdan küflenmiş bir kavun satın aldı. Kavunun üzerinde bulunan 'Penicillium Chrysogenum' olarak bilinen küf, Alexander Fleming'in ürettiği penisilin miktarının 3 bin katını üretiyordu. Mary Hunt ve ekibinin kavunun üstündeki küfü fark etmesi penisilinin hızla üretimine destek oldu. Takvimler 1944 yılını gösterdiğinde ise ABD'de üretilen toplam penisilin miktarı milyarlarca kat arttı. Hem ABD'de hem de İngiltere'de üretilen penisilin de II. Dünya Savaşı'ndaki askerlere götürüldü, böylece müttefik devletler adına savaşan askerlerin hayatı kurtuldu.